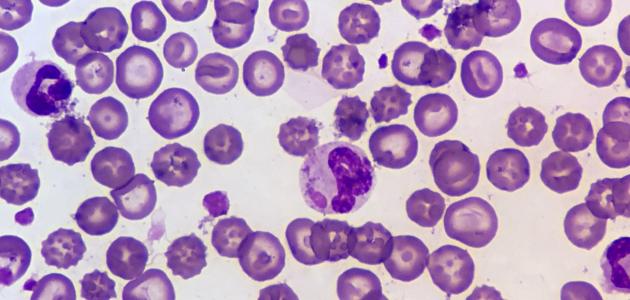

محتويات

تُمثل اليوريا (بالإنجليزية: Urea) أحد الفضلات التي تُرشّحها الكلى من الدم للتخلص منها، ويُعرف ارتفاع اليوريا في الدم طبيّاً بمصطلح اليوريميا (بالإنجليزيّة: Uremia)، وتُمثل هذه الحالة أحد أعراض الفشل الكلوي، إذ تفقد الكليتان في هذه الحالة قدرتهما على ترشيح الفضلات بشكلٍ صحيح؛ ممّا قد يؤدي إلى دخولها في مجرى الدم. يُعاني المرضى المُصابين باليوريميا في العادة من ارتفاعٍ في مستويات العديد من المواد؛ بما في ذلك البروتينات والكرياتينين (بالإنجليزيّة: Creatinine)، ممّا قد يؤثر في العديد من أجهزة الجسم.[١]
يُصاحب ارتفاع اليوريا في الدم ظهور مجموعة من العلامات والأعراض، نذكر منها ما يأتي:[٢]
- التّعب.
- الكسل.
- فقدان القدرة على التركيز.
- الحكّة المُستمرة.
- ارتعاش العضلات (بالإنجليزيّة: Muscle Twitching).
- جفاف الجلد، وتقشّره، إضافةً إلى تغيّر لونه ليُصبح باللون الأصفر.
- جفاف الفم، إضافةً إلى الشعور بطعم معدني.
- خروج رائحة نفس شبيهة إلى حدٍّ ما برائحة الأمونيا.
- فقدان الشهية.
- الغثيان.
- التقيؤ.
- الإسهال.
- الإمساك.
- اضطراب الجهاز العصبي، والجهاز التنفسي، والقلب، والأوعية الدموية، ممّا قد يتسبّب بالمُعاناة من الوذمة (بالإنجليزية: Edema)، أو ارتفاع ضغط الدم، أو التشنّجات، أو الفشل القلبي، أو الموت، وتجدر الإشارة إلى حدوث ذلك في المراحل المُتقدّمة.
يُعزى ارتفاع اليوريا في الدم إلى وجود ضرر شديد في الكِلى غير قابل للانعكاس والمُتمثل في كثيرٍ من الأحيان بالإصابة بأمراض الكِلى المُزمنة، وبشكلٍ عامّ يُمكن بيان أسباب اليوريميا على النّحو التالي:[٣]
- ارتفاع ضغط الدم.
- مرض الكلى المُتعدد الكيسات (بالإنجليزية: Polycystic kidney disease).
- مرض السّكري؛ سواء النّوع الأول أم الثاني.
- التهاب كبيبات الكلى (بالإنجليزية: Glomerulonephritis)؛ وتُمثل الكبيبات وحدات الترشيح في الكلى.
- التهاب الأنابيب الكلوية والهياكل المُحيطة بها.
- تضخّم البروستاتا.
- الإصابة بأنواع مُعينة من السّرطانات.
- حصى الكلى التي قد تتسبّب بانسداد المسالك البولية لفترةٍ طويلةٍ من الزمن.
- عدوى الكلى المُتكرّرة.
- ↑ “All you need to know about uremia”, www.medicalnewstoday.com, Retrieved 9-5-2019. Edited.
- ↑ “Uremia”, www.britannica.com, Retrieved 9-5-2019. Edited.
- ↑ “What Is Uremia?”, www.healthline.com, Retrieved 9-5-2019. Edited.